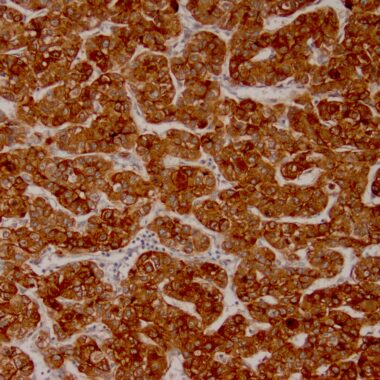

Zeta Glypican-3 Antibody. Zeta’s rabbit recombinant antibody recognizes Glypican-3 (GPC3), a glycosylphospatidyl inositol-anchored membrane protein, which may also be found in a secreted form. Zeta’s antibody against Glypican-3 (GPC3) has been identified as a useful tumor marker for the diagnosis of hepatocellular carcinoma (HCC), hepatoblastoma, melanoma, testicular germ cell tumors, and Wilm’s tumor. In patients with HCC, Glypican-3 (GPC3) is overexpressed in neoplastic liver tissue and elevated in serum, but is undetectable in normal liver, benign liver, and the serum of healthy donors. Glypican-3 (GPC3) expression is also found to be higher in HCC liver tissue than in cirrhotic liver or liver with focal lesions such as dysplastic nodules and areas of hepatic adenoma (HA) with malignant transformation. In the context of testicular germ cell tumors, Glypican-3 (GPC3) expression is up regulated in certain histologic subtypes, specifically yolk sac tumors and choriocarcinoma. A high level of Glypican-3 (GPC3) expression is also found in some types of embryonal tumors, such as Wilm’s tumor and hepatoblastoma, with a low or undetectable expression in normal adjacent tissue. In patients with thyroid cancer, expression of Glypican-3 (GPC3) is dramatically enhanced in certain types of cancers: 100% in follicular carcinoma and 70% in papillary carcinoma. Expression of Glypican-3 (GPC3) in follicular carcinoma is significantly higher than that of follicular adenoma. In contrast, Glypican-3 (GPC3) is not expressed in anaplastic carcinoma.
Zeta Corporation is a leader in recombinant monoclonal IVD antibodies for immunohistochemistry (IHC) offering 400+ tumor and tissue specific relevant products developed by a pathologist for pathologists. Visit Precision Recombinant Antibodies – IVD Antibodies – About Zeta Corporation (zeta-corp.com) to learn more about Zeta Corporation.